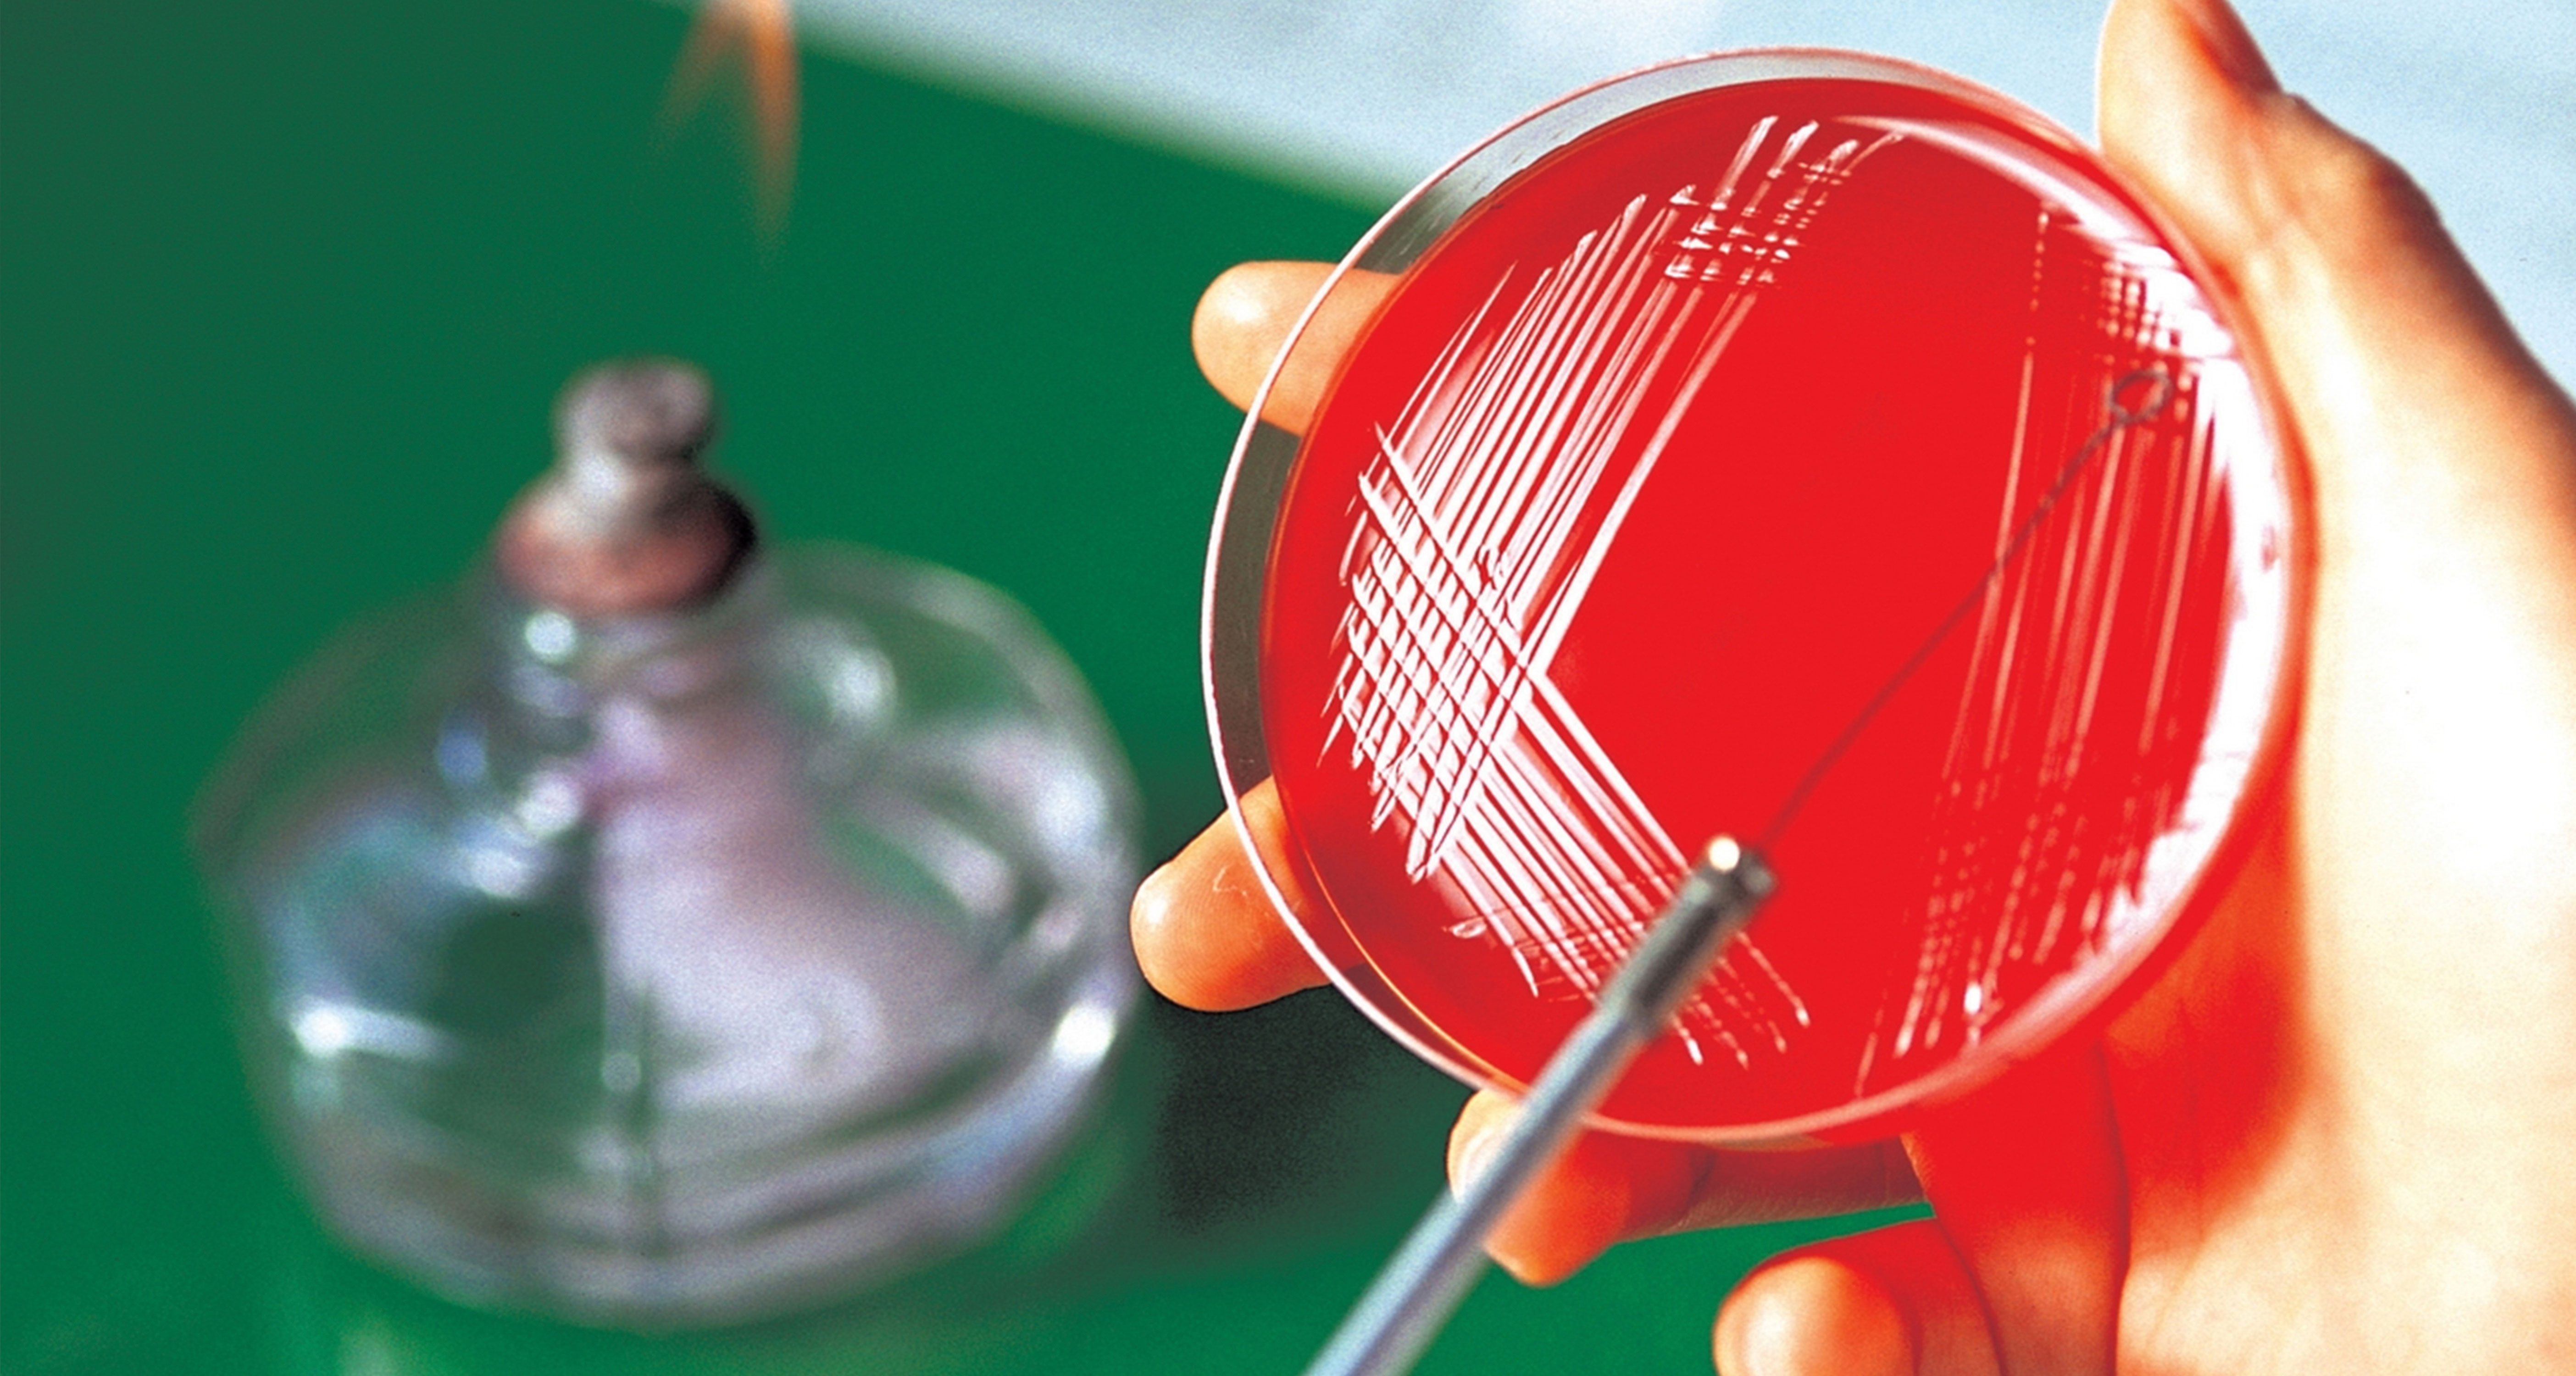
관련 이미지

이에 맞추어 임상병리학 분야도 거듭하여 발전하고 있습니다.
저희 임상병리학과는 이론적 의과학의 이해를 바탕으로 하여 임상병리학 전반에 지식을 갖춘 전문화된 임상병리사를 양성하는데 목표를 두고 있습니다.
	CLINICAL LABORATORY SCIENCE
정확한 진단, 미래를 보는 판단
- 임상병리학은
 - 인간의 건강증진을 목표로 의과학을 적용하여 질병의 진단, 경과, 치료효과 및 예후 등을 판단하는 데에 필요한 의학정보를 제공하는 학문입니다. 인류는 건강하게 오래 살기를 바라기에 계속되는 연구를 통하여 헬스케어 분야에 끊임없는 발전을 이루어 왔고, 이와 더불어 질병진단을 위해 첨단 의료기술과 진단기기를 개발하여 이용하고 있습니다. 따라서 임상진단과 관련하여 전문화된 임상병리사 양성이 절대적으로 필요합니다.

임상병리학을 전공한 후
임상병리학을 전공한 후에 환자의 건강을 책임지는 임상병리사로서 병원에서 근무하거나, 바이오헬스 분야에서 연구를 계속할 수 있고, 의과학의 한 분야에서 전문 보건의료인으로서 인류 복지를 위해 활동할 수 있습니다. 이러한 전문 보건의료인 양성을 위한 임상병리학과의 발전은 현재와 미래사회의 요구이기도 합니다.
	임상병리학을 전공한 후에 환자의 건강을 책임지는 임상병리사로서 병원에서 근무하거나, 바이오헬스 분야에서 연구를 계속할 수 있고, 의과학의 한 분야에서 전문 보건의료인으로서 인류 복지를 위해 활동할 수 있습니다. 이러한 전문 보건의료인 양성을 위한 임상병리학과의 발전은 현재와 미래사회의 요구이기도 합니다.